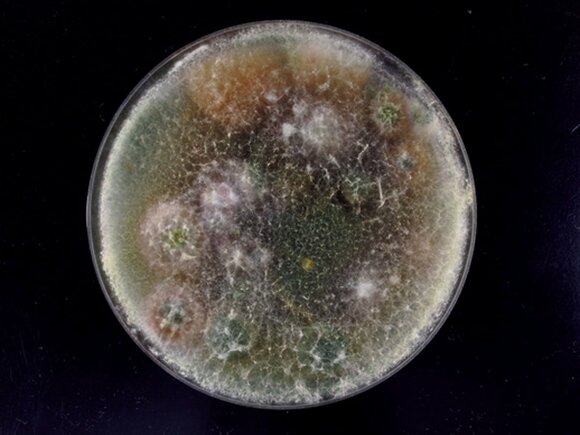
冷蔵庫野菜室カビ

気温と湿度が上昇するこの時期、カビ・ダニが活発になります。とくにキッチンなどの水回りは増殖しやすく、口に入れるものなのでかなり気になりませんか?
そこで、カビ・ダニ博士の川上裕司さんが、ESSE読者Hさんのお宅にお邪魔して、カビ・ダニが繁殖しやすく、見落としがちな場所を徹底チェック! 予防と対策については掃除のプロ・高橋敬子さんに教わってきました。
助けて! キッチンまわりは洗ったつもりでもカビや菌が大繁殖!
<冷蔵庫>野菜クズや手アカが栄養源に。低温でも油断大敵
すべての画像を見る(全8枚)まずは冷蔵庫をチェック。100平米当たり、野菜室は7個、ドアポケットは700個のアオカビを検出しました。「野菜室は、数は多くありませんが、食品汚染の原因になるカビなので危険です」と川上さん。
カビは低温でも死滅せずに繁殖します。「野菜クズや手アカ汚れがあると栄養源に。増殖したカビが庫内に拡散し、食品を汚染する心配があります」と川上さんは警鐘を鳴らします。Hさんは「衛生には気をつけていましたが、たしかに野菜室が少し心配で…」と反省しきり。
【退治法】
野菜クズなどは取り除き、消毒用エタノールをつけた布で庫内をふき取ります。パッキンの溝部分についた黒ズミは綿棒の先にエタノールをつけ、こすり落としてください。
【予防法】
汚れがつかないよう、野菜室には新聞紙を敷きつめ、こまめに交換を。ゴボウなど泥つきの野菜を入れるのはNG。調味料など食品の汚れはその都度、ふき取りましょう。
<食器洗いカゴ>水気を残したままだと食器にもカビの危険が!
「食器洗いカゴにヌメリがつくと、カビが繁殖し、食器への汚染が心配に」と川上さんの言うように、カゴや受け皿には水気を残さないことが大事。キッチンに消毒用エタノールを常備し、こまめに殺菌すると安心です。
【退治法】
カゴの縁や受け皿の汚れは、スポンジと台所用中性洗剤でこすり洗い。ヌメリなどがひどい場合は、塩素系漂白剤につけおきし、水で洗い流します。
【予防法】
一日の最後に受け皿にたまった水を捨て、洗いカゴの食器を取り出し、水気を残さない習慣に。乾いたら消毒用エタノールを全体にスプレーし、殺菌するとベターです。
<まな板>キズがあると、カビと細菌の繁殖の危険大。定期的に殺菌を
まな板はとくに注意したいアイテム! 川上さんは、「生の食材をのせるまな板は、汚れが残るとカビの原因になります。包丁などでまな板にキズがつくと、中でカビと細菌が繁殖します」と言います。使用後は洗剤で十分に洗い、定期的な殺菌を欠かさずにするのが鉄則です。
【退治法】
塩素系漂白剤にまな板をつけおきし、殺菌します。汚れ落としがないよう、まな板の表面は液を浸したふきんでおおうのがコツ。水でよく洗い流し、乾燥させます。
【予防法】
使うたびにスポンジと台所用中性洗剤で洗い、洗いカゴなどに斜めに置いて水気をよくきります。ときどき天日干しにし、殺菌を。風通しのいい場所で保管してください。
<排水口、三角コーナー>油断するとたちまちヌメリ、カビが繁殖。日々のケアはマスト
恐れていた排水口は、黒く汚染する黒色酵母様菌をはじめ、酵母菌、細菌を検出しました。「ヌメリの正体が酵母菌で、カビの前兆。早めのケアをしてください」と川上さんが言うほど、日ごろのお手入れが大事な箇所です。
いつも水気にさらされ、特にヌメリが発生しやすいスポットでもあります。「排水口のバスケットは洗っても、中までは…」とひるむHさんに、川上さんから「危険な状態。内部でカビや細菌が大繁殖していますよ」と厳しい指摘がありました。
【退治法】
ポリ袋に塩素系漂白剤の液をつくり、排水口のバスケットをつけおきし、ヌメリを除去。パイプ回りはブラシでこすります。三角コーナーも同様に行います。
【予防法】
一日の最後に食材のクズなどを捨ててからにし、水洗いします。2、3日に一度、排水口はバスケットとトラップを外し、スポンジなどでこすり、ヌメリを予防しましょう。
<スポンジ>洗剤や水気を残さない! 交換はこまめに
スポンジは洗い物があるたび、頻繁に水気にさらされてしまうものですが、「またあとで使うから、とスポンジに洗剤を含ませたままにすると、たちまち細菌が増殖。水きりがあまいのも細菌を呼ぶ原因です」と川上さんからの注意が入ります。においがついたり、古びたスポンジはいつまでも使わず、こまめに交換しましょう。
【退治法】
1か月に一度をめどに交換しますが、多少のヌメリは熱湯で除菌が可能。洗いおけなどにスポンジを入れて熱湯をかけ、手で触れる熱さになったら水気を絞り、天日干しにしましょう。
【予防法】
使用後は水でよくすすぎ、ぎゅっと絞って水気をきります。水ぎれのいいスポンジ置きを使うか、ピンチでつるし、通気性のよいところで保管します。
<食品ストック>粉や麺類はダニの好物。汚染されるとアレルギーの危険が
ついつい長く保存してしまいがちな食品ストック。安全かと思いきや、数か月前に開封して輪ゴムで留めていたお好み焼きの粉には1g当たり1匹のコナヒョウヒダニが検出されました。「調理していたら大変なことになっていました!」と驚くHさんに対し、「粉類や乾麺は、ダニの好物。開封した袋に入れたままだと、ダニがつきやすくなります」と川上さんが言います。
そのほかは、液体調味料もカビに用心です。使用後は液だれをふいてからしまって。どちらも口にするものなので、細心の注意を払いましょう。
【退治法】
開封後の調味料は、カビ・ダニが入り込む恐れが。とくに袋に入れたままの粉類や乾麺は注意。一度発生したダニを取り除くのは不可能なので、すぐに処分をしましょう。
【予防法】
開封した粉類や乾麺は密閉容器に入れて保管します。口回りに粉がついたら、必ずふき取ってからしまうこと。梅雨どきから夏の間は冷蔵庫で保管すると安心です。
<食器棚、シンク下>つめ込みすぎは避け、通気性をよくして
「扉のある収納内は空気がよどみ、意外にカビやすい場所。ものはつめ込まず、掃除がしやすい配置を心がけて」。食器は水気をよくふき取ってからしまうこと。排水管のあるシンク下も通気をよくしないとカビてしまいます。
【退治法】
中のものを取り出し、消毒用エタノールを布につけてカビに押し当てるようにふき取ります。水でかたく絞った布でふいたら、しばらく扉をあけて、湿気を追い出してください。
【予防法】
棚には新聞紙を敷きつめ、汚れを見つけたらすぐに交換します。湿気がこもりやすいシンク下は、ときどき扉をあけ放ち、換気するようにしましょう。
※本記事はESSE2015年7月号の記事を抜粋したものです